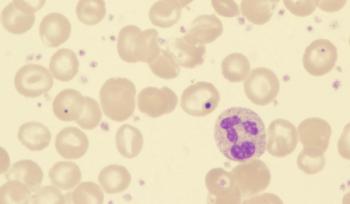

Adverse Effects
Latest News
Latest Videos

Shorts



Podcasts
More News

Thomas Hope, MD, asserts that legislation aimed at resolving infiltration-related AEs does not address any relevant clinical issue.

Cancer cachexia can be deadly, and due to AEs or the tumor itself, scientists are now looking at molecular subtypes to inform treatment decisions.

Vickie Baracos, PhD, discusses recent results that investigate cancer cachexia and how the RNome of the muscle plays a role.

Adam Friedman, MD, FAAD, discusses systemic barriers to timely dermatologic consultation for patients with cancer.

Adam Friedman, MD, FAAD, discusses essential communication strategies for oncologists to address patient fears about dermatologic adverse effects.

The Chemo Mouthpiece had favorable outcomes when used during and after treatment with chemotherapy among a range of patients with various types of cancer.

A survey found that patients believed dermatologic AEs were more prevalent with anti-cancer therapies than what has been reported.

The intravenous formulation of tocilizumab-anoh for CRS is expected to launch in the US on August 31, 2025.

ATR04-484 showed inhibition of both methicillin-sensitive and methicillin-resistant Staphylococcus aureus bacteria strains, which are associated with rash.

Scalp cooling may enhance patients’ quality of life when managing hair loss associated with cancer treatment.

Diverse dermatologic AEs, such as hair and nail toxicities, can be associated with various cancer treatments.

BMI, serum albumin, and G8 screening tool scores were all factors correlated with the likelihood of experiencing a grade 3 or higher AE.

Toxicity complications were assessed between single- and multiple-treatment modalities for patients with localized prostate cancer.

Quality of life improvements can be made if clinicians better understand auditory attention decay after cancer treatment in pediatric patients with cerebellar tumors.

One of the most predictable toxicities of autologous stem cell transplantation for multiple myeloma — even more so than mucositis — is hair loss.

When pembrolizumab is combined with immunotherapies, the incidence of grade 3 to 5 toxicities increases, especially with anti–CTLA-4 combinations.

“We’ve seen with the initial anti-CTLA-4 ipilimumab experience that, as time went by, we were better at identifying and managing toxicities,” stated Omid Hamad, MD.

A pooled analysis found pembrolizumab has a discontinuation rate of 12.7%, and a major key to handling it is maintaining good communication between the doctor and the patient.

All patients who received HT-001 in the phase 2a CLEER-001 trial showed significant skin toxicity improvements by 6 weeks.
Results from the phase 3 AVA-PED-301 trial support the FDA decision for avatrombopag in pediatric thrombocytopenia.

The novel drug showed promise in helping to decrease chemotherapy-induced peripheral neuropathy for those who had received prior chemotherapy.

Study results suggest follow-up with hypercholesterolemia control and audiological assessments for cisplatin-treated patients with cancer.

Safety data further support datopotamab deruxtecan as a new treatment option in metastatic hormone receptor–positive, HER2-negative breast cancer.

Additional research may be necessary to validate the efficacy of telehealth interventions in clinical activities for patients with cancer.

Lack of energy, difficulty with sleeping, and pain were some of the most common symptoms reported in older patients with cancer.















































































